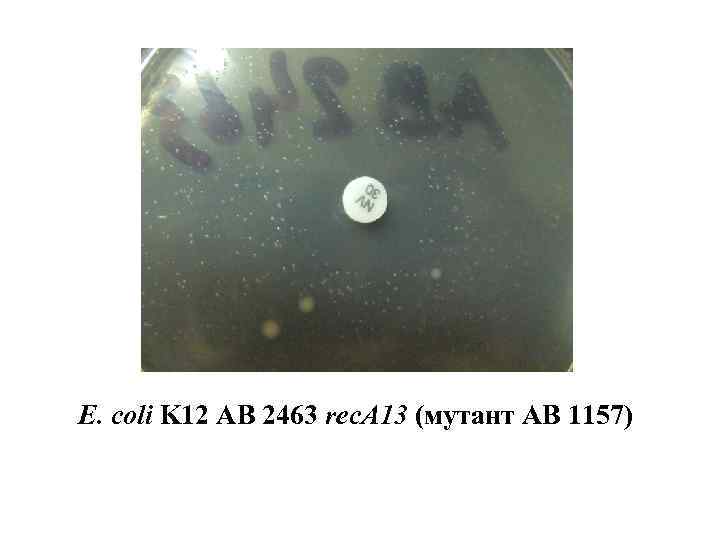
E. сoli K 12 AB 2463 rec. A 13 (мутант АВ 1157)
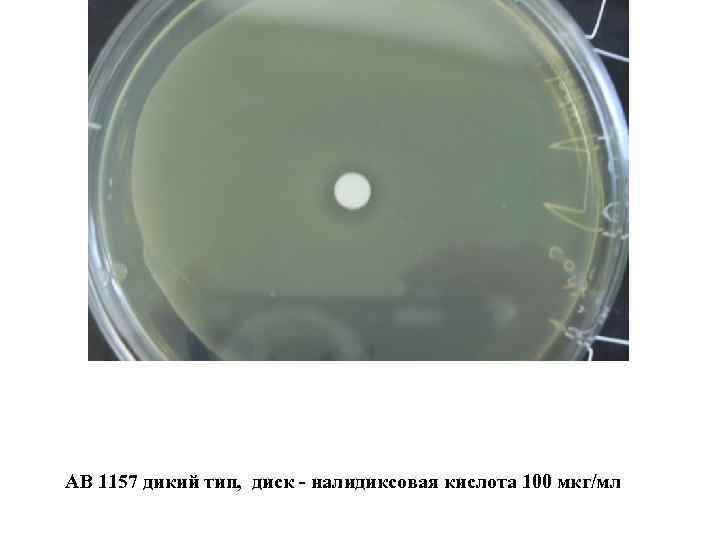
AB 1157 дикий тип, диск - налидиксовая кислота 100 мкг/мл
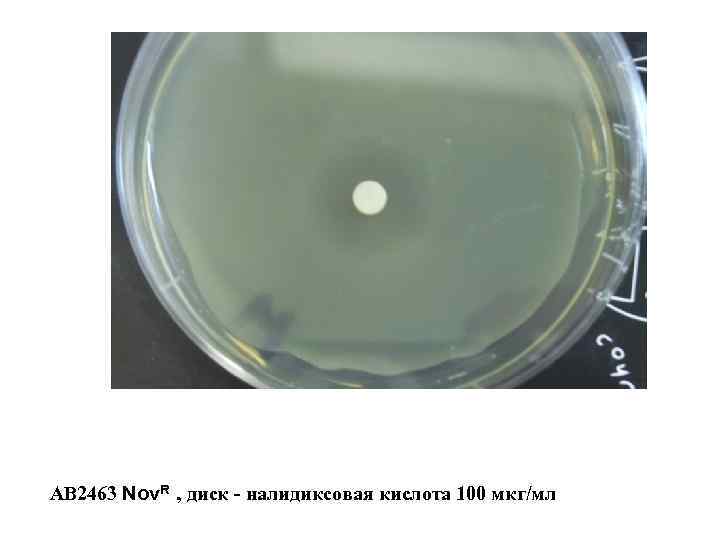
АВ 2463 Nov. R , диск - налидиксовая кислота 100 мкг/мл

Смирнов recA, polA, uvrD(E), gyrAB.ppt
- Количество слайдов: 27
 Памяти Александра Семёновича Саенко посвящается
Памяти Александра Семёновича Саенко посвящается
 Принципиальная схема Уотсона-Крика
Принципиальная схема Уотсона-Крика
 Джон Кэйрнс
Джон Кэйрнс
 Белки, участвующие в репликации ДНК, и функциональные связи между ними
Белки, участвующие в репликации ДНК, и функциональные связи между ними
 Схема репликации ДНК
Схема репликации ДНК
 Схема репликации ДНК
Схема репликации ДНК
 B I Sinzinis, G B Smirnov, A S Saenko Repair deficiency in Escherichia coli UV-sensitive mutator strain uvr 502. Biochemical and Biophysical Research Communications 08/1973; 53(1): 309 -16. Synzynys BI, Il'ina TP, Smirnov G. B. , Saenko AS Degradation, synthesis and reparation of the DNA in cells of E. coli UVR 502 following UV irradiation. Radiobiologiia 1974 Jan-Feb; 14(1): 13 -20
B I Sinzinis, G B Smirnov, A S Saenko Repair deficiency in Escherichia coli UV-sensitive mutator strain uvr 502. Biochemical and Biophysical Research Communications 08/1973; 53(1): 309 -16. Synzynys BI, Il'ina TP, Smirnov G. B. , Saenko AS Degradation, synthesis and reparation of the DNA in cells of E. coli UVR 502 following UV irradiation. Radiobiologiia 1974 Jan-Feb; 14(1): 13 -20
 Saenko AS, Synzynys BI, Smirnov GB Study of the ability of a DNA polymerase mutant E. coli K 12 pol A 1 for elimination of single-stranded breaks in DNA caused by methyl methanesulfonate. Mol Biol 1972 Sep. Oct; 6(5): 526 -32
Saenko AS, Synzynys BI, Smirnov GB Study of the ability of a DNA polymerase mutant E. coli K 12 pol A 1 for elimination of single-stranded breaks in DNA caused by methyl methanesulfonate. Mol Biol 1972 Sep. Oct; 6(5): 526 -32
 Smirnov GB, Filkova EV, Skavronskaya AG, Saenko AS, Sinzinis BI. Loss and restoration of viability of E. coli due to combinations of mutations affecting DNA polymerase I and repair activities. Mol Genet. 1973 Mar 1; 121(2): 139 -50.
Smirnov GB, Filkova EV, Skavronskaya AG, Saenko AS, Sinzinis BI. Loss and restoration of viability of E. coli due to combinations of mutations affecting DNA polymerase I and repair activities. Mol Genet. 1973 Mar 1; 121(2): 139 -50.
 Доменная с труктура ДНК-полимеразы I E. coli. A – взаимное расположение доменов. I – 5’-нуклеазный домен, II – (3’ 5’)-экзонуклеазный домен, III – ДНК-полимеразный домен. Стрелка соответствует кленовскому фрагменту ДНК-полимеразы I. B – мотивы полимеразного домена, консервативные среди бактериальных ДНК-полимераз I. Эти мотивы имеют следующие консенсусные последовательности: 699 hhhh. Dhhx. Ehx 712 (A), 754 Rpxx. Kxxxh. Ghh. Y 766 (B) и 876 hhxh. HDЕhxx. Е 888 (С) - , где h – гидрофобный остаток, х – произвольный остаток, р – преимущественно R (нумерация остатков ДНК-полимеразы I E. coli)
Доменная с труктура ДНК-полимеразы I E. coli. A – взаимное расположение доменов. I – 5’-нуклеазный домен, II – (3’ 5’)-экзонуклеазный домен, III – ДНК-полимеразный домен. Стрелка соответствует кленовскому фрагменту ДНК-полимеразы I. B – мотивы полимеразного домена, консервативные среди бактериальных ДНК-полимераз I. Эти мотивы имеют следующие консенсусные последовательности: 699 hhhh. Dhhx. Ehx 712 (A), 754 Rpxx. Kxxxh. Ghh. Y 766 (B) и 876 hhxh. HDЕhxx. Е 888 (С) - , где h – гидрофобный остаток, х – произвольный остаток, р – преимущественно R (нумерация остатков ДНК-полимеразы I E. coli)

 1. Определить сравнительную чувствительность мутанта и дикого типа к новобиоцину. 2. Определить возможность и частоту мутаций устойчивости к новобиоцину у бактерий мутанта и дикого типа. 3. Сравнить локализацию мутаций к новобиоцинустойчивости в бактериях мутанта и дикого типа.
1. Определить сравнительную чувствительность мутанта и дикого типа к новобиоцину. 2. Определить возможность и частоту мутаций устойчивости к новобиоцину у бактерий мутанта и дикого типа. 3. Сравнить локализацию мутаций к новобиоцинустойчивости в бактериях мутанта и дикого типа.
 E. сoli K 12 AB 1157 дикий тип
E. сoli K 12 AB 1157 дикий тип
E. сoli K 12 AB 2463 rec. A 13 (мутант АВ 1157)
E. сoli K 12 AB 2463 rec. A 13 (мутант АВ 1157)
 Дикий тип Крупн. Мелк. rec. A Кривые УФ-инактивации Nov. R мутантов rec. A мутанта АВ 2463
Дикий тип Крупн. Мелк. rec. A Кривые УФ-инактивации Nov. R мутантов rec. A мутанта АВ 2463
 1. Какое отношение имеет АТФ-аза, обслуживающая субъединицу А ДНКгиразы, к жизнеспособности мутанта rec. A? и 2. Как может мутация к Nov. R повлиять на репарацию, точнее на её отсутствие в мутанте rec. A?
1. Какое отношение имеет АТФ-аза, обслуживающая субъединицу А ДНКгиразы, к жизнеспособности мутанта rec. A? и 2. Как может мутация к Nov. R повлиять на репарацию, точнее на её отсутствие в мутанте rec. A?
AB 1157 дикий тип, диск - налидиксовая кислота 100 мкг/мл
AB 1157 дикий тип, диск - налидиксовая кислота 100 мкг/мл
 АВ 2463 rec. A 13, диск - налидиксовая кислота 100 мкг/мл
АВ 2463 rec. A 13, диск - налидиксовая кислота 100 мкг/мл
АВ 2463 Nov. R , диск - налидиксовая кислота 100 мкг/мл
АВ 2463 Nov. R , диск - налидиксовая кислота 100 мкг/мл
 Налидиксовая кислота
Налидиксовая кислота
 Белок Rec. A
Белок Rec. A

 Rec. A – The Evolution Gene Об эволюции: «It is a process that happens because various proteins interact with the DNA to recombine it. And in this regard, Rec. A is the star. » Mike Gene
Rec. A – The Evolution Gene Об эволюции: «It is a process that happens because various proteins interact with the DNA to recombine it. And in this regard, Rec. A is the star. » Mike Gene
 Оценивая частоты использования механизма гомологичной рекомбинации клеткой для реактивации остановившихся репликационных вилок, Сох установил, что именно эта функция рекомбинации является основной. Почти каждая репликационная вилка бактериальной клетки, растущей в обычных аэробных условиях, останавливается из-за столкновения с повреждением ДНК. Причем это происходит не только в условиях стресса, например, при облучении ультрафиолетом, а в нормальных условиях аэробного роста, когда SOS-функции клетки не индуцируются. Вот почему белок Rec. A является столь важным для клетки.
Оценивая частоты использования механизма гомологичной рекомбинации клеткой для реактивации остановившихся репликационных вилок, Сох установил, что именно эта функция рекомбинации является основной. Почти каждая репликационная вилка бактериальной клетки, растущей в обычных аэробных условиях, останавливается из-за столкновения с повреждением ДНК. Причем это происходит не только в условиях стресса, например, при облучении ультрафиолетом, а в нормальных условиях аэробного роста, когда SOS-функции клетки не индуцируются. Вот почему белок Rec. A является столь важным для клетки.
 Into the life and death: Rec. A a WISE factor working to integrate survival and evolution in Escherichia coli
Into the life and death: Rec. A a WISE factor working to integrate survival and evolution in Escherichia coli

 Спасибо за внимание
Спасибо за внимание


